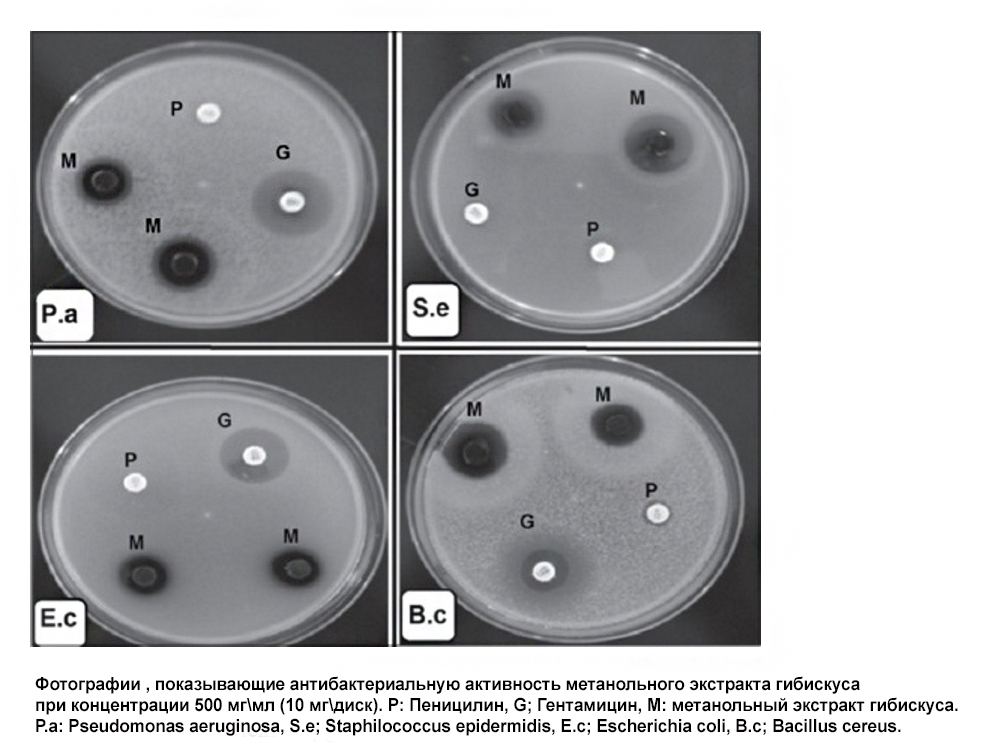

Come l'ibisco cura la cistite?
Chi ha mai avuto a che fare con la cistite? Le statistiche affermano che ogni donna vive mediamente 0,5 episodi di cistite all’anno. In ogni famiglia, oltre agli antibiotici, c’è sempre un metodo infallibile “di casa” per curarla. Nella mia famiglia, ad esempio, il rimedio è una borsa dell’acqua calda applicata sull’addome e diverse tazze di karkadè caldo. Funziona sempre.
Il calore aiuta sicuramente ad alleviare i sintomi, ma non cura l’infezione. E se fosse il karkadè a fornire un effetto terapeutico? Durante il mio ultimo “episodio”, aggrappata alla mia amata bottiglia calda, ho deciso di cercare pubblicazioni scientifiche sulle proprietà terapeutiche dell’ibisco, o Hibiscus sabdariffa, noto anche come tè karkadè. Non mi aspettavo grandi risultati, ma mi sbagliavo: esiste una moltitudine di studi che esplorano le proprietà antibatteriche dell’ibisco! In questo articolo presenterò estratti degli studi più promettenti e, naturalmente, condividerò i link agli articoli originali delle riviste mediche.

Come il karkadè cura la cistite?
Un’analisi completa dei componenti chimici dell’ibisco è stata completata nel 2003 e, da allora, Hibiscus sabdariffa è inclusa nei registri medici delle piante officinali.
Di seguito sono riportate le formule strutturali dei principali composti organici attivi presenti nella rosa del Sudan:
- composti fenolici come eugenolo e acido protocatecuico;
- composti polifenolici come antociani, quercetina e antocianidine;
- acidi organici e vitamine (
fonte
).

L’estratto di ibisco ha dimostrato un potenziale antibatterico contro i seguenti batteri:
- Escherichia coli ATCC 25922
- Salmonella ATCC 5174
- Klebsiella pneumoniae ATCC 27736
- Proteus vulgaris ATCC 49132
- Pseudomonas aeruginosa ATCC 27853
- Staphylococcus aureus ATCC 25923
- Staphylococcus epidermidis ATCC 49461
- Bacillus cereus ATCC 10876
- Aureus, Bacillus stearothermophilus, Micrococcus luteus, Serratia marcescens, Clostridium sporogenes, E. coli, Klebsiella pneumoniae, Bacillus cereus e Pseudomonas fluorescence ( fonte ).
L’estratto di ibisco è paragonabile in efficacia alla gentamicina ma, per ragioni ancora poco chiare, non induce resistenza batterica, a differenza degli antibiotici di sintesi. Gli studi dimostrano che l’estratto sopprime la crescita batterica.
Ingredienti antibatterici dell’ibisco
Le proprietà antibatteriche dell’estratto sono attribuite a diversi componenti fitochimici attivi biologicamente presenti nella pianta, quali: alcaloidi, flavonoidi, saponine, composti fenolici, triterpeni, steroli, terpenoidi, antrachinoni, tannini e steroidi. Tuttavia, non è ancora stato individuato con precisione quale di questi elementi sia il principale responsabile dell’effetto osservato. Sono necessari ulteriori studi tossicologici per analizzare i vari tipi di estratti (acquoso, metanolico, etanolico). Dettagli ulteriori sono disponibili nella fonte .
Efficacia dell’estratto di ibisco contro le infezioni sistemiche
L’estratto di Hibiscus sabdariffa inibisce la crescita di biofilm di funghi resistenti agli antibiotici, come Candida albicans, responsabili di infezioni delle vie urinarie. Normalmente, la candida è facilmente trattabile e considerata un lievito a bassa patogenicità. Tuttavia, in particolari condizioni, può evolvere in un’infezione sistemica - candiduria - che risulta estremamente difficile da trattare, portando a gravi complicazioni a causa della formazione di biofilm resistenti agli antibiotici disponibili (ad esempio ceppi resistenti al fluconazolo).
L’ibisco impedisce la formazione di biofilm da parte di ceppi di Candida albicans resistenti al fluconazolo. Questa conclusione è supportata da questo studio condotto su campioni raccolti da pazienti con candiduria ricorrente. L’alta attività di H. sabdariffa contro questi ceppi fornisce una base scientifica per il suo utilizzo nella medicina tradizionale.
L’assunzione di estratto di ibisco, associata a un antibiotico, previene lo sviluppo di resistenza microbica e micotica agli antibiotici stessi, anche se il meccanismo d’azione è ancora in fase di studio. Un’ipotesi è che i composti fenolici ricchi di ferro interferiscano con proteine essenziali dei microbi. Un altro possibile meccanismo potrebbe consistere nell’inibizione dei processi cellulari che aumentano la permeabilità della membrana plasmatica, causando la fuoriuscita di ioni dalle cellule batteriche.
H. sabdariffa contiene un particolare composto polimerico noto come proantocianidina. Studi indicano che la proantocianidina derivata dal mirtillo rosso inibisce la formazione del biofilm di C. albicans. Tuttavia, l’antociano presente nell’ibisco non è stato ancora testato. Dettagli dello studio sono disponibili a
questo link
.

Gli studi sull’estratto continuano, ma manca ancora un consenso sul principale principio attivo. Nuovi ceppi batterici e fungini vengono costantemente introdotti nelle ricerche.
Esistono tre principali modalità di preparazione dell’estratto: acquoso, basato su metanolo o su etanolo. Ogni metodo produce diverse concentrazioni di sostanze attive, ma è improbabile sapere quale metodologia sia stata adottata per la produzione delle capsule in commercio (sono a conoscenza solo del marchio Aflazin, la cui istruzione non specifica il metodo di estrazione utilizzato). In ambito domestico, abbiamo a disposizione l’estrazione acquosa sotto forma di tè karkadè o l’estrazione etanolica, simile al metodo descritto per
la menta
.

Qualunque sia la modalità di utilizzo dell’ibisco che sceglierete, essa rappresenterà un valido supporto nel trattamento della cistite, nonché una possibile alternativa al trattamento farmacologico, in base ai risultati delle ricerche “sperimentali” e non solo ai consueti e autorevoli aneddoti “a me funziona!”.



